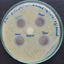

FOR AUTHORS
Search
Search Results
##search.searchResults.foundPlural##
-
The distribution of Culex mosquitoes in Coimbatore, Tamil Nadu, India
4074Downloads: 915HTML: 2147 -
Mosquitocidal and water purification properties of Ocimum sanctum and Phyllanthus emblica
2946Downloads: 2194HTML: 639 -
Mosquito larvicidal and silver nanoparticles synthesis potential of plant latex
4433Downloads: 1507HTML: 1787 -
Physical characteristics and reproductive performance in Aedes (Diptera: Culicidae)
2352Downloads: 1250HTML: 1065 -
Survivorship and longevity of Diamesa mendotae Muttkowski (Diptera: Chironomidae) under snow
2659Downloads: 1135HTML: 181
1 - 49 of 49 items